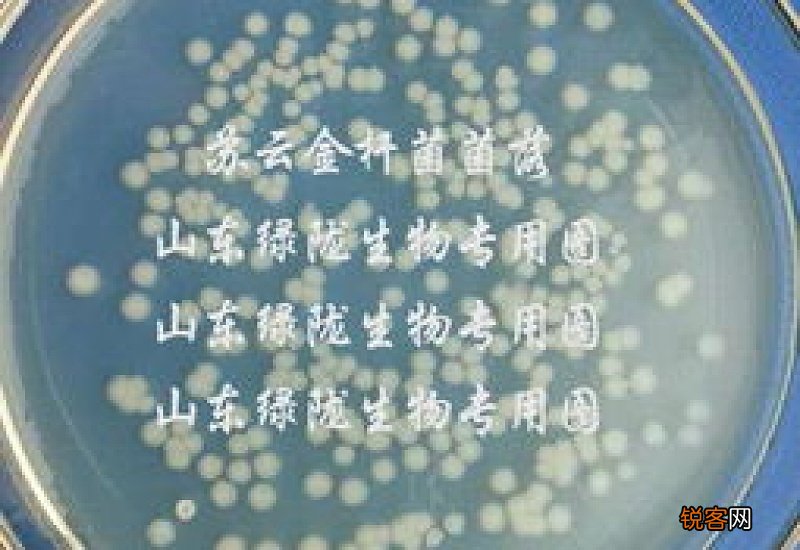
芽孢杆菌怎么活化

文章插图
1.芽孢杆菌的活化方法是:菌种活化 。
2.按照菌:红糖和水按0.5:5:25左右的比例浸泡两个小时以上,浸泡时用小的气泵曝气更佳 。
3.菌种耗氧 。
4.枯草芽孢繁殖需要大量氧气,使用时间一般是晴天上午9到11点,保证氧气充足 。
5.温度适宜 。
6.使用温度是25℃以上为宜,水温低,菌种生长缓慢,无法迅速形成优势种,效果不理想 。
7.芽孢杆菌属细菌较大(4~10μm),革兰氏阳性、是严格需氧或兼性厌氧的有荚膜的杆菌 。
8.该属细菌的重要特性是能够产生对不利条件具有特殊抵抗力的芽孢 。
【芽孢杆菌怎么活化】9.芽孢杆菌属可分为以下亚群:多黏芽孢杆菌、枯草芽孢杆菌(包括蜡样芽孢杆菌和地衣芽孢杆菌)、短芽孢杆菌和炭疽芽孢杆菌 。
- 油菜可以和鸡蛋一起做菜吗 怎么用油菜和鸡蛋做菜
- 单纯的醉驾怎么处罚 单纯的醉驾怎么处罚的
- 刀片服务器怎么拆出来 刀片服务器怎么查序列号
- 猫生完小猫不吃东西怎么办
- 如何从内网渗透到内网服务器? 内网怎么渗透到内网服务器
- 遇到三菱空调故障代码1PC怎么办?3个处理方法帮助你
- 手上烟黄太重怎么洗掉
- 遇到三菱空调温度显示l0怎么办?3个处理方法帮助你
- 遇到松下空调开机显示eo怎么办?3个处理方法帮助你
- 遇到博世壁挂锅炉显示ea怎么办?3个处理方法帮助你
